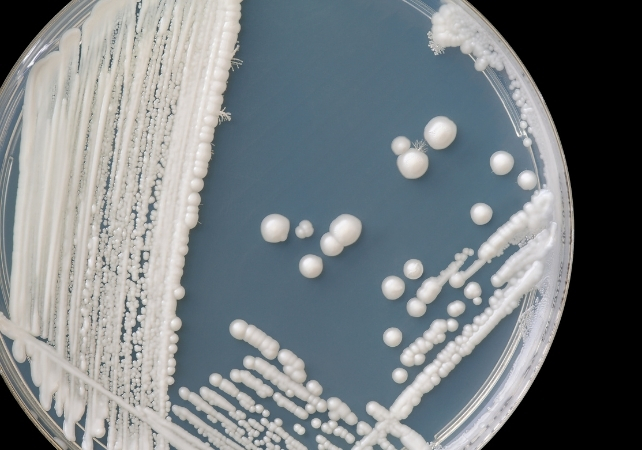

Deși infecțiile cu drojdie sunt în mod normal tratate cu ușurință cu medicamente antifungice, un număr tot mai mare de specii de Candida devin rezistente la aceste medicamente – inclusiv specia care cauzează candidoza.
Potrivit Centrelor pentru Controlul și Prevenirea Bolilor din SUA, aproximativ 7% dintre toate probele de sânge de Candida testate sunt rezistente la medicamentul antifungic fluconazol, medicamentul de primă linie folosit pentru tratamentul majorității infecțiilor cu Candida.
Acest lucru înseamnă că există mai puține opțiuni de tratament pentru chiar și infecțiile obișnuite cu candidoză – făcându-le mai dificil de tratat. De asemenea, înseamnă că infecțiile mai severe cu Candida, care pot apărea la persoane cu un sistem imunitar slăbit sau care iau cursuri lungi de antibiotice, vor deveni și mai greu de gestionat.
Rezistența la antifungice ar putea contribui, de asemenea, la creșterea candidozei recurente (infecții care continuă să revină). Aceasta afectează aproximativ 138 de milioane de femei la nivel mondial, dar se estimează că va crește la 158 de milioane de persoane până în 2030.
Peisajul rezistenței la antifungice s-a schimbat dramatic în ultimele decenii.
În anii 2000, rezistența la antifungice era rară. Fluconazolul funcționa bine pentru majoritatea infecțiilor cu Candida albicans, mai puțin de 5% dintre acestea fiind rezistente la acesta.
Dar Candida albicans este un microorganism foarte adaptabil, care poate dezvolta cu ușurință rezistență la antifungice în anumite condiții.
Cercetările arată că rezistența printre Candida albicans a crescut în ultimii opt ani cel puțin. Un studiu mic efectuat la pacienți din Egipt a descoperit că în 2024, aproape 26% dintre izolatele de Candida albicans din probele de sânge erau rezistente la fluconazol.
Cu toate acestea, mai multă cercetare este necesară pentru a înțelege dacă această situație este similară la nivel mondial.
Candida poate dezvolta rezistență la medicamentele antifungice prin mutații genetice, care le fac mai puțin susceptibile la antifungice sau le ajută să reducă eficacitatea medicamentului.
Candida se poate proteja, de asemenea, de medicamentele antifungice formând biofilme rezistente. Aceste straturi lipicioase de celule fungice blochează accesul medicamentelor, ajută fungusul să pompeze înapoi orice medicamente care au pătruns bariera și permit unor celule să se ascundă într-o stare de repaus până când tratamentul se încheie.
Candida poate, de asemenea, să modifice structura moleculelor vizate de antifungice pentru a împiedica medicamentele să se lege eficient.
Motivul principal pentru care infecțiile cu Candida devin mai greu de tratat este că fungusul se adaptează pentru a supraviețui medicamentelor antifungice.
Dar această rezistență nu apare întâmplător. Există mai mulți factori care contribuie la această problemă, printre care utilizarea abuzivă și excesivă a medicamentelor antifungice (nu doar de către oameni, ci și în agricultură) și numărul limitat de medicamente antifungice eficiente disponibile (care sunt greu de dezvoltat și costisitoare).
Sursa: [Link către articolul original](link către sursa originală a informației)

Editor RevistaSanatatii.ro. Isi doreste ca activitatea lui sa aduca speranta milioanelor de oameni bolnavi din Romania, sa le aline suferintele si sa le ofere speranta.